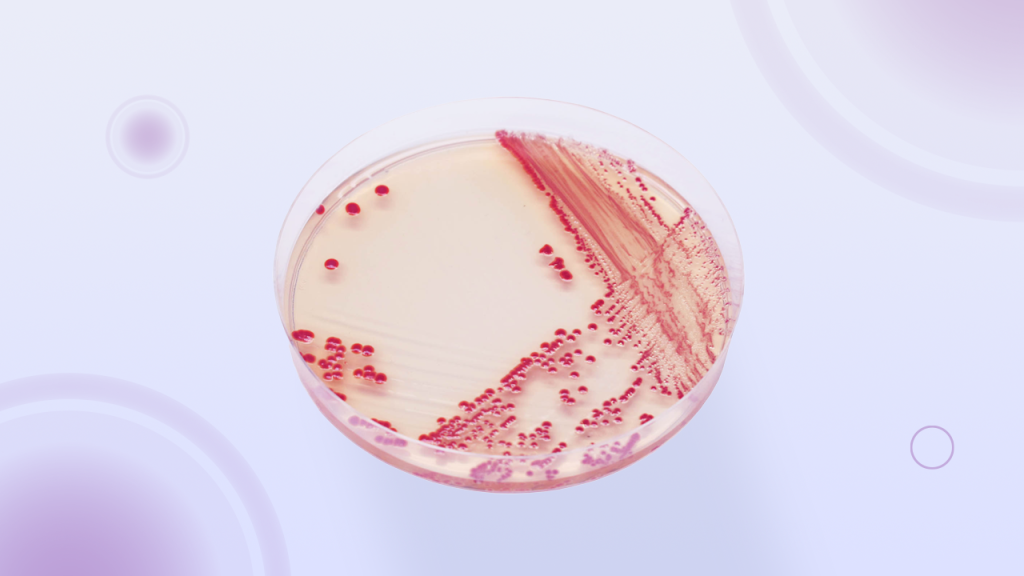

O Mercado de Insumos de Microbiologia: Tendências, Desafios e Oportunidades

As tendências, desafios e oportunidades do mercado de insumos de microbiologia para o ano de 2025
Material de Referência Certificado para Laboratórios: Lab-Elite ™ CRM e Epower™ CRM

De acordo com o ISO Guide 30:2015, o material de referência certificado (MRC) é um material de referência (MR) caracterizado por um procedimento metrologicamente válido para uma ou mais propriedades especificadas, acompanhado de um certificado que fornece o valor de propriedade especificada, sua incerteza associada e uma declaração de rastreabilidade metrológica.
EZ-PEC™ Solução Quantitativa para Testes de Eficácia em Laboratórios

A Plastlabor oferece ao setor farmacêutico uma solução eficiente que economiza tempo e recursos, além de ajudar a cumprir a Farmacopeia e outros padrões e diretrizes, mesmo em procedimentos complexos como os testes de eficácia antimicrobiana.
Determinação Quantitativa de MIC com fita de gradiente de concentração de antimicrobianos

O MIC Test Strip é a ferramenta essencial para laboratórios e profissionais de saúde que buscam determinar com precisão a concentração mínima inibitória (MIC) de agentes antimicrobianos.
Rotina de Vigilância

Cultura de Vigilância (ou rastreamento): Detecção de colonização de microrganismos multirresistentes em amostras clínicas.
Rotina de Urocultura

Urocultura: Exame solicitado no Laboratório de Microbiologia Clínica que detecta o agente etiológico causador da infecção, e que após a identificação do microrganismo permitirá o teste de sensibilidade (antibiograma) para a terapêutica.
Anaeróbios: Características e Mudanças do BrCast/Eucast 2023

A sobrevivência de bactérias anaeróbias depende de sua sensibilidade ao oxigênio, requisitos nutricionais, coleta apropriada, meio de cultura, tempo e temperatura de incubação.
Meios cromogênicos
Os meios cromogênicos são diferenciais e seletivos, permitindo a identificação presuntiva do patógeno em menor tempo.
Síndrome de choque tóxico estreptocócico

A Síndrome do choque tóxico estreptocócico (SST) é uma condição grave e incomum em Pediatria.
Importância da Listeria na indústria de alimentos

Todos os alimentos destinados ao consumo requerem a aplicação de boas práticas de fabricação, desde a produção primária até o consumidor final.
Novos Antibióticos: um desafio frente à resistência antimicrobiana

A emergência de microrganismos resistentes às diversas classes de antimicrobianos tem sido progressiva, tornando-se uma ameaça à saúde pública em todo o mundo.
Isolados Ambientais: um olhar cuidadoso

Podemos observar um olhar cuidadoso, que vem aumentando ultimamente no contexto de isolados ambientais.